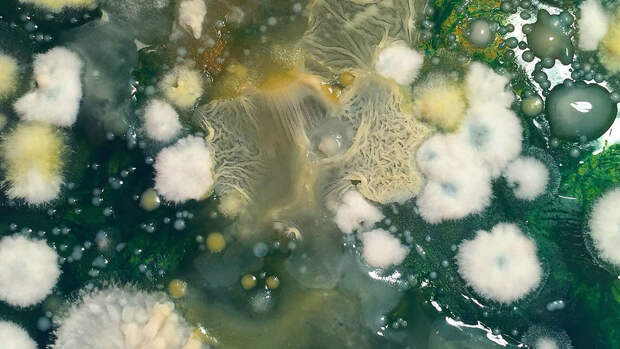

На Международной космической станции (МКС), в зоне самого старого модуля, российского функционально-грузового блока "Заря", обнаружили превышение допустимой концентрации плесени в воздухе, сообщает РИА "Новости" со ссылкой на Центр подготовки космонавтов.
"Содержание фрагментов плесневых грибов в воздушной среде превышало нормативный показатель", - указано в исследовании специалистов Института медико-биологических проблем РАН и Центра подготовки космонавтов.
Ученые указывают на результаты одной из шестнадцати проб, которые были сделаны космонавтами на российском сегменте МКС в конце января 2021 года.
В модуле "Заря", в районе панели №103, было обнаружено 110 колониеобразующих единиц на кубометр в воздуха при допустимой концентрации в 100 единиц.
В исследовании не уточняется, какие меры были приняты космонавтами для устранения плесени.
Ранее космонавт заявил о высокой степени износа российского сегмента МКС.
Свежие комментарии